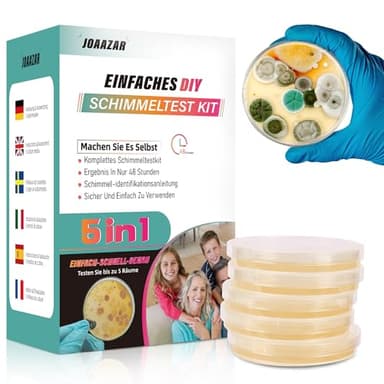
Schimmeltest Kit für ZuHause - Schimmelpilz Test für 5 Räume - Schimmelpilz Schnelltest Raumluft Kit für die Luftqualität in Innenräumen - Inklusive Identifikationsleitfaden & Anleitung

10 Beste Schimmelentferner Test Stiftung Warentest in Deutschland
Getestet und bewertet: Die Top 10 Schimmelentferner Test Stiftung Warentest-Angebote mit Expertenbewertungen von 8,1 bis zur perfekten 10
Mai 2026 Ausgabe
|
1
9.7

TFA Dostmann
TFA Dostmann SCHIMMEL DETEKTOR Infrarot-Thermometer mit Taupunktermittlungund Doppellaser, Blau, L110 x B72 x H240 mm
Kostenloser Versand
Fazit des Editors:
“Dieser schimmelentferner test stiftung warentest ist der beste, den wir getestet haben. In Bezug auf Qualität, Marke und Preis könnten wir uns nichts Besseres wünschen.”
Hauptmerkmale
- Schimmeldetektor: Erkennt Schimmelgefahr durch Ermittlung von Raumklima und Taupunkt, mit Bargraph Anzeige und Warn LED Ampel, warnt mit Signalton
- Messverfahren: Berührungsloses Messen der Oberflächentemperatur mit sehr schneller Messung (1 Sekunde) und ohne direkten Oberflächenkontakt, d.h. selbst Messungen bei hohen Spannungen oder aggressiven Materialien möglich
- Temperaturmessung: Thermometer für flüssige, pastöse und halbfeste Materialien, besonders im elektrischen und mechanischen Bereich verwendbar; z.Bsp. Heizung, Klima, Lüftung oder KFZ Diagnose
- Großer Messbereich: Durch die Infrarotmessung sind sehr große Messbereiche möglich, hier von -50 bis 260° Celcius, außerdem; dazu liegt eine sehr geringe Temperaturbeeinflussung des Messobjektes vor
- Abschalt-Automatik: Durch die Abschaltautomatik schaltet sich das Thermometer automatisch nach 15 Minuten Nichtbenutzung aus und kann durch einfache Betätigung des Messknopfes wieder aktiviert werden
Preis anzeigen
Heute von 397 Personen gewählt
2
9.5

airself
Schimmeltest + Thermohygrometer: Zum Check der Schimmelbelastung für bis zu 6 Räume. Inkl. analogem Thermo-Hygrometer
Kostenloser Versand
Hauptmerkmale
- Schimmelpilztest zur einfachen Heimanwendung: Sie erhalten ein praktisches Test-Set, mit dem Sie die Luftqualität bezüglich Schimmelpilzsporen bei Ihnen zu Hause ganz einfach überprüfen können.
- Einfache Testauswertung durch Bebrütung der Nährböden und Zählen der Entstandenen Schimmelpilzkolonien. Praktisches Messprotokoll und Beispiele zur Anwendung.
- Testinhalt: 6 Nährböden für einen quantitativen Schimmeltest im Sedimentationsverfahren. Ausführliche Broschüre rund ums Thema Schimmel inkl. Anleitung und Auswertungsprotokoll.
- Inklusive Thermohygrometer zur Bestimmung der Luftfeuchtigkeit. Ideal zur Vorbeugung gegen Schimmelbefall. Keine Batterien benötigt. Zum Aufhängen oder Stellen, inkl. informativer Broschüre.
- Luftfeuchtigkeitsmesser: Überwachen Sie Ihr Raumklima mit farbig markierten Zonen. Skala zur Messung der relativen Luftfeuchtigkeit von 0-100 % sowie eine weitere zur Temperaturmessung von 0-40 °C.
Preis anzeigen
3
9.5

AGO SAUBERKEIT FÜR HAUS UND GARTEN!
AGO 500ml Schimmelentferner mit Pinsel & Handschuhen – stärker als herkömmliche Sprühreiniger/hochkonzentriertes Anti Schimmel Mittel/Schimmelentferner Fugen Dusche
Kostenloser Versand
Hauptmerkmale
- SCHNELLE WIRKUNG Der Schimmel Entferner von Ago beseitigt Schimmelpilze, Algen, Stockflecken & Bakterien die Wirkung ist sofort sichtbar. Der Wandschimmel Entferner wirkt gleichzeitig desinfizierend.
- VIELSEITIG ANWENDBAR Der Schimmelpilz-Entferner ist im Innen- und Außenbereich einsetzbar. Mit dem Schimmelreiniger halten Sie Ihr Fliesen & Fugen sowie Wände in Ihrem Bad, Haus und Sauna schimmelfrei.
- EFFEKTIV Das Schimmelmittel ist hochkonzentriert mit einer bis zu 10fach stärkeren Wirkung wie herkömmliche Sprühreiniger. Dank des Pinsels kann der Silikonfugen Schimmelentferner präzise auf betroffenen Stellen aufgetragen werden.
- UMFANGREICHES SORTIMENT - Zur vorbeugenden Nachbehandlung empfehlen wir ebenfalls den AGO Schimmelstop anzuwenden. Die Ago Schimmelprodukte sind auch im praktischen Set erhältlich.
- SICHERHEIT - Biozidprodukte vorsichtig verwenden. Vor Gebrauch stets Etikett und Produktinformationen lesen. BAuA N-72983
Preis anzeigen
4
9.2

airself
Schimmeltest für zu Hause - Schimmelpilz Test für bis zu 6 Räume - Schimmelpilz Schnelltest zur Einschätzung der Luftqualität hinsichtlich einer Schimmelpilzbelastung in Innenräumen
Kostenloser Versand
Hauptmerkmale
- Original airself Schimmeltest: Mühelos die Luftqualität zuhause testen, inkl. 6 Nährböden, ausführlicher Anleitung, Auswertungsprotokoll, Bewertungsskala, weiterer Informationen zum Thema Schimmel.
- Erste Ergebnisse in nur 3 Tagen: Der Schimmelpilz Schnelltest bietet rasch Hinweise zur Sporenbelastung der Raumluft. Die komplette Auswertung ist nach 10 Tagen fertig einfach und ohne Laboranalyse.
- Einfache Anwendung prüfen Sie ohne Fachwissen die Luftqualität in bis zu 6 Räumen. Die Anleitung führt Sie Schritt für Schritt ideal für Mieter, Hausbesitzer und Allergiker.
- Orientierender Schimmeltest Die Nährböden sammeln Schimmelsporen in der Raumluft per Sedimentationsverfahren. Ermitteln Sie so den Belastungsgrad mit der beiliegenden Skala.
- Durchdachtes Produkt made in Germany: der Test wird hierzulande gefertigt und beruht auf einer erprobten Testausstattung. Die Nährböden sind ein Naturprodukt - daher bitte möglichst schnell verwenden.
Preis anzeigen
5
9.0
Spare 3%

AirCheck
Schimmeltest Wohnung – Schimmeltester für 6 Räume – Schimmelpilz Schnelltest mit Nährboden zur Einschätzung der Raumluft
3% RabattKostenloser Versand
Hauptmerkmale
- Original Schimmeltest von AirCheck: Testen Sie mühelos Ihre Raumluft, inkl. 6 Nährböden, Anleitung, Auswertungsprotokoll, Bewertungsskala und Expertenwissen zum Thema Schimmel.
- Schnelle Ergebnisse schon nach 3 Tagen wissen Sie mehr! Der Schimmelpilz Schnelltest liefert rasch erste Hinweise zur Schimmelbelastung der Luft. Nach 10 Tagen ist die Auswertung fertig einfach und ohne Labor.
- Kinderleichte Anwendung! Der Test prüft die Luftqualität in bis zu 6 Räumen. Die Schritt-für-Schritt-Anleitung führt Sie sicher zum Ergebnis ideal für Mieter, Hausbesitzer und Allergiker.
- Raumlufttest per Sedimentationsmethode: Die Nährböden sammeln Schimmelsporen aus der Luft. Sie bestimmen den Belastungsgrad anhand der gewachsenen Kolonien mit der Bewertungsskala selbst.
- Made in Germany verlassen Sie sich auf Präzision & durchdachtes Zubehör! Tipp: Die Nährböden sind ein Naturprodukt - bitte für beste Ergebnisse möglichst rasch nach dem Kauf verwenden.
Preis anzeigen
6
8.8

PUFAS
SchimmelX Schimmel Entferner ""chlorFREI"" 0,750 L
Kostenloser Versand
Hauptmerkmale
- Biozidprodukte vorsichtig verwenden.
Preis anzeigen
7
8.6
Spare 10%

JOAAZAR
Schimmeltest Kit für ZuHause - Schimmelpilz Test für 5 Räume - Schimmelpilz Schnelltest Raumluft Kit für die Luftqualität in Innenräumen - Inklusive Identifikationsleitfaden & Anleitung
10% RabattKostenloser Versand
Hauptmerkmale
- KOMPLETTES SCHIMMELTEST KIT: Die JOAAZAR Schimmeltest Kit für Zuhause die Luftqualität im Haus, Oberflächen und HLK-Systeme, einschließlich 10 Agar-Petrischalen, 10 Wattestäbchen, einem detaillierten Identifikationsleitfaden. Dieses vielseitige Schimmel Schimmelpilz Test Raumluft Kit ermöglicht eine detaillierte Überprüfung der Luftqualität in Ihrem gesamten Haus und identifiziert verschiedene Schimmelarten. Es ermöglicht eine einfache Probenentnahme und liefert genaue und zuverlässige Ergebnisse für ein beruhigendes Gefühl!
- VIELSEITIGE INNENTESTS: Mit der Flexibilität, beide Innenumgebungen zu beurteilen. Das DIY Schimmelpilz Schimmeltest Raumluft Kit für Zuhause ist für eine umfassende Umweltprüfung ausgestattet und eignet sich für die Durchführung von Innentests. Es erkennt effektiv unsichtbaren Schimmel in Wohnbereichen, vom Dachboden, Keller, Auto, Schlafzimmer, Auto, Küche, Büro und HLK-System bis hin zu allen Oberflächentests im Innenbereich!
- DREI TESTMETHODEN FÜR UMFASSENDE ANALYSE: Das Schimmelpilz Schnelltest Schimmeltest Kit für Zuhause von JOAAZAR bietet einen vielseitigen Ansatz zur Schimmelerkennung in Ihrem Zuhause. Entscheiden Sie sich für einen Test der Luftqualität in Innenräumen, um die Gesamtatmosphäre zu untersuchen, verwenden Sie die Probenahmemethode für Klimaanlagen und Heizungen für eine detaillierte Überprüfung Ihrer Klimaanlagen oder wählen Sie die Oberflächenproben-Testmethode, um sichtbaren Schimmel direkt zu erkennen und zu analysieren. Dieses anpassbare Luftschimmeldetektor-Kit gewährleistet eine gründliche Schimmelbewertung in jedem Problembereich.
- 2-3 TAGE SICHTBARE SCHIMMELERKENNUNG: Identifizieren Sie Schimmel nahtlos mit dem Schimmeldetektor für Zuhause von JOAAZAR. Dieses effiziente und zuverlässige Schimmeltest für Zuhause bietet einen unkomplizierten Raumluft Schimmeltest prozess für Zuhause und stellt sicher, dass Sie Schimmel sicher erkennen können. Erhalten Sie klare, sichtbare Ergebnisse in nur 48 Stunden für schnelles und sicheres Handeln.
- SICHERHEIT: Unser Schimmeltester Kit für Zuhause wurde entwickelt, um Ihnen die Sicherheit und Gewissheit zu geben, die Sie verdienen. Es testet auf das Vorhandensein von Tausenden von Schimmel, schützt Ihre Familie und sorgt für das Wohlbefinden Ihrer Lieben. Vertrauen Sie darauf, dass Ihr Schimmeltest Kit für Zuhause Ihnen die Sicherheit bietet, die Sie für eine gesunde und sorgenfreie Umgebung benötigen.
Preis anzeigen
8
8.3

The Tester
Schimmeltester für Wohnung - Schimmelmessgeräte Raumluft - Test für Schimmelsporen in der Luft - Schimmelpilz test - Schimmeltest für Zuhause - The Tester
Kostenloser Versand
Hauptmerkmale
- SCHNELLER SCHIMMELNACHWEIS - Zur zuverlässigen Erkennung von Schimmel in Innenräumen, auf Oberflächen oder in Klimaanlagen.
- EINFACHE ANWENDUNG - Petrischale vorbereiten, Test platzieren, 48 Stunden inkubieren lassen und Ergebnisse visuell prüfen.
- VIELSEITIGE ERKENNUNG - Identifiziert u. a. Alternaria, Aspergillus niger, Cladosporium, Penicillium und Rhizopus.
- KOMPLETTES SET - Enthält Petrischale mit Nährboden, Reagenslösung, Wattestäbchen, Anleitung und Retailverpackung.
- OHNE LABOR ERGEBNISSE ERHALTEN - Benutzerfreundlich, sicher für den Heimgebrauch und mit klarer Interpretationshilfe.
Preis anzeigen
9
8.1
Spare 27%
Mellerud
MELLERUD Schimmel Frei Haftgel Aktivchlor - 1 x 0,25 l | Schimmelentferner Bad - Chlorhaltiges, tropffreies Anti-Schimmel-Gel für Fliesen, Fugen, Wand, Decke u. v. m.
27% RabattKostenloser Versand
Hauptmerkmale
- Bei Schimmelbefall muss präzise und intensiv reagiert werden - der Schimmelentferner wirkt effektiv gegen Pilzansätze, Stockflecken und Bakterien & besticht mit einer leichten, tropffreien Anwendung
- Der Schimmelentferner lässt sich gezielt auf betroffene Stellen im Haus, in der Sauna oder im Schwimmbad aufbringen und hilft dabei, Schimmelbefall vorzubeugen
- Schimmelentferner Bad - Das Gel eignet sich für zahlreiche Oberflächen wie z. B. Fliesen, Fugen, Wände, Decken, Mauerwerk, Holz, Kunststoffe, Silikonfugen und vieles weitere
- Bleichend und desinfizierend: Den Schimmelentferner kräftig schütteln, vom Körper weg dünn aufsprühen und 1 Stunde einwirken lassen - mit Wasser oder einem feuchten Tuch abwaschen
- Lieferumfang: 1 x 0,25 l MELLERUD Schimmel Frei Haftgel Aktivchlor / Mit Chlor, langhaftend und hochwirksam / Bleicht und desinfiziert / Für zahlreiche Oberflächen
- Biozidprodukte vorsichtig verwenden. Vor Gebrauch stets Etikett und Produktinformationen lesen. BAuA-Reg-Nr.: N-79451
Preis anzeigen